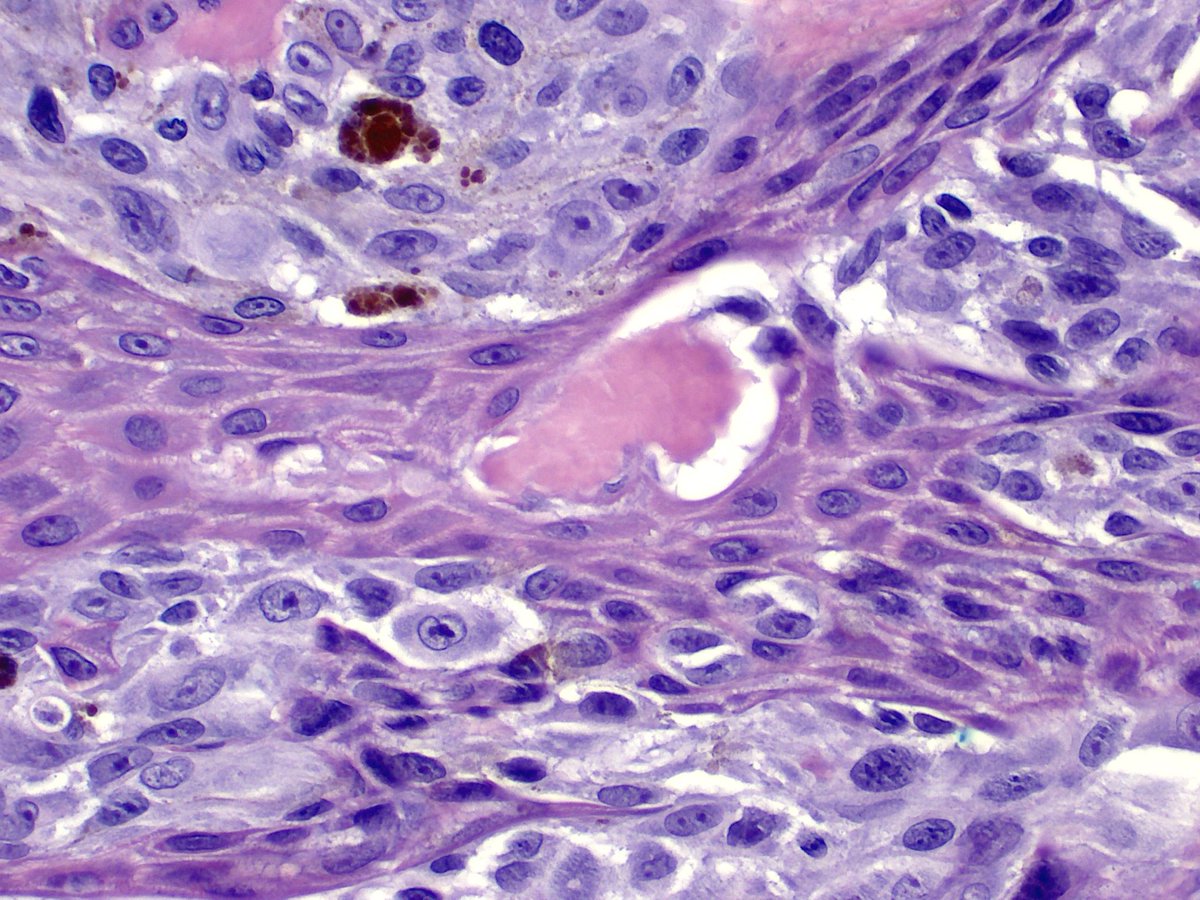
I don't understand why these eosinophilic blobs, named after Hideko Kamino, should be such a useful finding.  But even in the age of fusions, aCGH and NGS they still hold up very well!  Some musings from 20 years ago... pubmed.ncbi.nlm.nih.gov/11481532/
#dermpath #pathology #dermatology

Benjamin Wood
@benjaminawood
Dermatopathologist, PathWest Laboratory Medicine and University of Western Australia. #dermpath
ID: 804201620674252800
http://scholar.google.com.au/citations?hl=en&user=9FqJleMAAAAJ&view_op=list_works&sortby=pubdate 01-12-2016 05:53:02
440 Tweet
1,1K Followers
80 Following





First Pan-NTRK IHC out of our lab on a FISH proven NTRKoma. Looks like this will be an easy optimisation! Thanks to Chris van Vliet! #dermpath #pathology #dermatology









The Australasian Dermatopathology Society meeting will be a virtual event. 3 days of great live content, including lectures from Jerad Gardner, MD and Dirk Elston. Content available on demand following the meeting. All our #dermpath #dermatology and #pathology friends welcome.